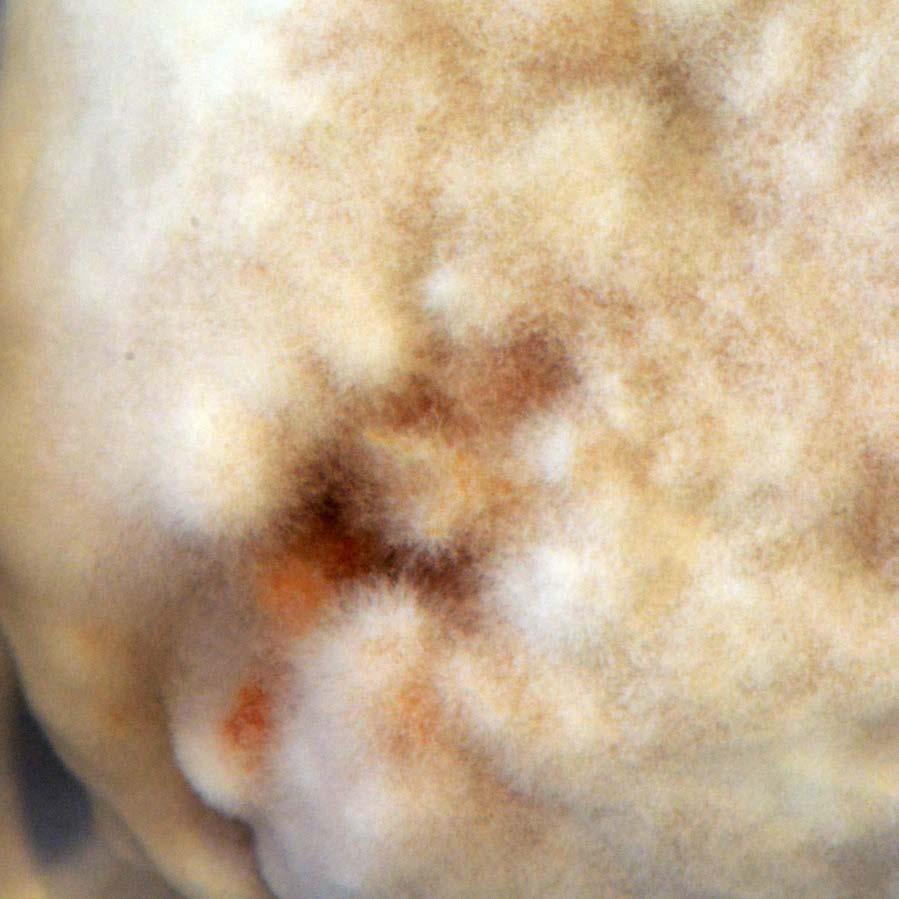

waste /weɪst/ (noun) unwanted or unusable material, substances, or by-products. (verb) use or expend carelessly, extravagantly, or to no purpose.




waste /weɪst/ (noun) unwanted or unusable material, substances, or by-products. (verb) use or expend carelessly, extravagantly, or to no purpose.
Decomposing Temporalities is an inquiry into the underside of cities, where waste is concealed and confined to the periphery. The project exercises the extended mind theory through biological, indigenous and artificial intelligence to reorient wastewater treatment in urban morphologies. In the face of climate change, extreme flooding threatens London’s wastewater treatment facilities. Through mycelium’s bio-intelligence and indigenous cosmotechnics, the project constellates waste treatment not as a utility under threat, but an integral part of dynamic urban ecologies. These dynamics manifest in a aqaumarket that facilitates secondary waste treatment through mycofiltration and aquaculture whilst also being a point of exchange, habitation, fluctuation and negotiation.
This chapter looks at the history of London waste water system, its current state and the foreseeable effects to it by Climate Change.
As Pasquero and Poletto (2019) Waste, decay, digestion and dissolution are some of their most intense processes and a critical part of their circularity; these processes often constitute the dark side of urban ecology.” London’s Victorian waste treatment system is not unique to this matter.
During the 18th century, sewage was disposed of on the streets. In the 1840s, it became compulsory for raw sewage to be disposed through the sewers into the Thames River (Cook 2001). According to Cook, the Thames was the source of domestic water, which then caused city wide contamination from sewage- borne diseases. This sparked a media campaign through newspapers and journals to cleanse the Thames water (fig x-x).
The waste treatment system was engineering by Joseph William Bazalgatte (1819-91) according to the morphology and technics of London. It materialised after the industrial revolution, and therefore was a product of massive scale production which allowed for pumping stations and treatment works to be available. Waste treatment thus became a utility, devoid of value and divorced from the ecosystem unless as a negative inconvenience.

 Fig [1] The silent highwayman: Your money or your life, 1858. propaganda
Fig [2] Cross-section of Victoria Embankment, engraving, 1867 (Illustrated London News', 1867)
Fig [1] The silent highwayman: Your money or your life, 1858. propaganda
Fig [2] Cross-section of Victoria Embankment, engraving, 1867 (Illustrated London News', 1867)























According to the UK government’s GIS data, the Lea River has one of the lowest water qualities in London, making vulnerable its surrounding publically open water bodies.
Additionally, as predicted by Climate Central (2022), this area including the Walthamstow wetlands will be under threat by flooding, and potentially permanently submerged under water by 2070. To combat both degraded water quality and flooding, eight radical geoengineering models were developed. These models aimed to test the urban landscape at Walthamstow wetlands against water decentralisation, water infiltration, and capacity to host habitat diversity. With decentralised water systems, an urban space can reduce surface runoff accumulation at centralised water bodies. The models tested proved that by integrating porosity within urban morphology, further open spaces can facilitate infiltration and combat flooding whilst serving varying combinations of urban and ecological habitat diversity. Model I hosts the most potential to use flooding as a mechanical resource to treat wastewater with multiple communal outputs.
Within the proposed artifical landscape, four of London’s biomes were identified: moorlands, highlands, woodlands, and wetlands. The wetland biome in the proposed artificial landscape depicts attributes to serve as part of an ecological waste treatment.

 fig [7] Walthamstow wetlands aerial photograph
fig [7] Walthamstow wetlands aerial photograph











 Figure[8] 8 Radical geo-engineering models, model I detail w decentralisation w infiltration habitat diversity
Figure[8] 8 Radical geo-engineering models, model I detail w decentralisation w infiltration habitat diversity































































 Buzzards
Grouses
Red Deers
Foxes
Sand Lizzard
Owls Hares
Roe Deers Voles
Figure[10] London's biomes evident on artificial landscape
Breams
Dragon Flies Otters
Buzzards
Grouses
Red Deers
Foxes
Sand Lizzard
Owls Hares
Roe Deers Voles
Figure[10] London's biomes evident on artificial landscape
Breams
Dragon Flies Otters


 Figure[12] Wetland Biome Morphology detail
Figure[11] Architectural Morphology
Figure[12] Wetland Biome Morphology detail
Figure[11] Architectural Morphology
There are currently 8.7 million known organisms on planet earth. Yet, human beings consider their own intelligence as not only superior but singularly relevant. In this chapter, the concept of the exploded mind is employed to borrow the waste existence lens of other humans and nonhumans beyond the western canon. As Yuk Hui (2019) conceptualises, there are multiple ways of doing things in different societies which means that technology is not universal, instead it comprises of multiple pluralities - cosmotechnics. Therefore, waste [treatment] occurs in plurality as well. In this part of the paper, artificial intelligence, indigenous and biological intelligence are used to negotiate the place of waste [water] in the city with the aims of concepualising new cosmotechnics the redesign our relationship with waste.
The project uses computational methods to vowelise the artificial landscape, exploring a new material relationship between waste treatment and architecture. These relationships are further explored through the Bheri aquaculture (indigenous, mycelium (biological), and cycelGAN (artificial).



 Figure[13] Voxelisation of architectural morphology
Figure[13] Voxelisation of architectural morphology

 Figure[14] Metabolisation of voxel through cycleGAN
Figure[14] Metabolisation of voxel through cycleGAN

Figure[17] Biological intelligence mycelium and waste treatment
Figure[17] Biological intelligence mycelium and waste treatment






Mycelium’s ability to treat waste and facilitate decomposition (or the metamorphosis of nutrients) inspired the study of its wastewater treatment potential. According to the River Wandle Trust, mycelium can be used to treat wastewater through mycofiltration: the usage of mycelium filled hessian sacks distributed along a water channel to treat waste water. In this process, mycelium breaks up and utilizes the nutrients in the water to grow, removing them from the water and improving its quality. Mycofiltration coupled with the Bheri aquaculture system can result in waste treatment that is not divorced from urban ecosystems, but a vital member of it.
Subsequent to mycofiltration, the mycelium and substrate can be processed within the pond system as an architectural materialmygregate. Through its fibrous structure, mycelium acts as a binding agent of its substrate comprising of agricultural and manufacturing waste – sawdust and hay (Ongpeng Maximino C et al, 2020). The resulting mygregate becomes an extension of the voxelised relationship between ground and foreground, aggregated to form a negotiation of diverse forms and shapes. The mygregate is sourced from mycofiltration, cleaned, then moulded in a two-part 3D printed mould and grown over three weeks in a still air box inside a greenhouse. It is then removed from the mould and allowed to further grow in the still room, until it is dehydrated to prevent any further growth.
Through a continuous process of developing, testing and improving the mygregate prototype, the process of making architecture become intertwined in what Anne Willis (2006) describes as the fabrication of the human or human design. By employing architectural design processes to include the nurturing and growing of living micro-organisms, we design new relations between humans and non-humans, ultimately formulating a post-human state.

 Figure[19] Mycelium prototype - mygregate
Figure[19] Mycelium prototype - mygregate
100mm 70mm
100mm
PROTOTYPE COMPONENT 1




100mm 70mm
PROTOTYPE COMPONENT 2




70mm
PROTOTYPE COMPONENT 3

BAKED MYCELIUM PROTOTYPE
PROTOTYPE MOULD





















prototype /ˈprˈˈtˈtˈˈp/ Develop Test Improve

















The proposed urban morphogenesis utilises an extended mind to designing waste treatment as a utility into both ecologic and urban technics that redesign the relationship between humans and waste, humans and non-humans and humans and themselves. The artificial landscape proposal in the wetland biome suggests wastewater treatment can become negotiated architecture, agriculture marketplace and habitat.
Waste treatment design as a part of urban ecologies, allows spaces for the negotiated aggregations of spaces that redesign human and urban relationships with waste. The proposed landscape increases urban porosity through open spaces and water basins that embrace flooding [not resist] by facilitating water infiltration, vegetation and fish farming through aquaculture. The prototyping and aggregation can thus occur as a negotiation of these various factors, accumulating as architecture and reclining as mulch to curate diverse urban habitats.
Therefore, within this space, architecture is up for bargaining. It hangs at the mercy of the aggregation of biological, indigenous, artificial and human intelligence. In this exploded intellectual project, its designers also thus have agency. As implied in the writings of Anne Willis, if humans renegotiate the place of waste in the city, those waste technologies will further redesign what it means to be human – post human.

 Figure[25] Mycelium growth pattern
Figure[25] Mycelium growth pattern






PHASE E: SEMI CAPACITY GROWTH
PHASE F: FULL GROWTH OF MYCELIUM
Figure[26] Simulation of non-linear mycelium growth in mould - thresholds




PHASE H: FLUCTATION OF MYCELIUM DEFENSE WITH COMPETITION



 Figure[27] Growth aggregation of aquamarket defined by thresholds mycofiltration infiltration aggregation
Figure[27] Growth aggregation of aquamarket defined by thresholds mycofiltration infiltration aggregation








MYGREGATE AGGREGATION 01
MYGREGATE AGGREGATION 02








MYGREGATE AGGREGATION 03
MYGREGATE AGGREGATION 04

MYGREGATE AGGREGATION 05
MYGREGATE AGGREGATION 06
MYGREGATE AGGREGATION 07
MYGREGATE AGGREGATION 08
MYGREGATE AGGREGATION 09
























Figure 1: Cross-section of Victoria Embankment, engraving, 1867 (Illustrated London News', 1867)
Figure 2: The silent highwayman: Your money or your life, 1858. propaganda
Figure 3: Greater London Urban Context
Figure 4: Climate Central Flooding Projections - Open Space vs Treatment Plants proximity networks
Figure 5: London's Wastewater Treatment aesthetic & Infrastructure
Figure 6: Flooding in London's Wastewater Treatment and surrounding areas.
Figure 7: Walthamstow weltands aerial photograph
Figure 8: Radical geo-engineering models, model I detail
Figure 9: CycleGAN epoch test and generation of model I
Figure 10: London's biomes evident on artificial landscape
Figure 11: Architectural Morphology
Figure 12: Wetland Biome Morphology detail
Figure 13: Voxelisation of architectural morphology
Figure 14: Metabolisation of voxel - cycleGAN
Figure 15: cycleGAN machine learning epochs
Figure 16: Indigenous Intelligence - Bheri Aquaculture
Figure 17: Mycelium: Biological intelligence waste treatment
Figure 18: Mycelium: Generation growth of mycelium 1-2
Figure 19: Mygregate prototype
Figure 20: Mygregate prototype making and aggregation
Figure 21: Mygregate prototype generation 1 and 2
Figure 22: Mygregate prototype in mould
Figure 23: Fully grown mycelium prototype
Figure 24: Mygregate prototype aggregation
Figure 25: Mycelium growth pattern
Figure 26: Simulation of mycelium growth in mould - thresholds
Figure 27: Growth ggregation of aquamarket defined by thresholds
Figure 28: Morphogenisis phase C - Aquamarket
Figure 29: Aquamarket section
Figure 30: Aquamarket mygregate aggregation simulation
Figure 31: Aquamarket 01
Figure 32: Aquamarket 02
Figure 33: Aquamarket 03
Figure 34: Aquamarket 04
Figure 35: Aquamarket 05
...05 ...05 ...06 ...07 ...08 ...08 ...10 ...11 ...12 ...13 ...14 ...14 ...16 ...17 ...18 ...19 ...20 ...21 ...22 ...23 ...24 ...25 ...26 ...27 ...29 ...30 ...31 ...32 ...33 ...34 ...35 ...36 ...37 ...38 ...39 ...40 ...41
Boyno, Gökhan, and Semra Demir. ‘Plant-Mycorrhiza Communication and Mycorrhizae in Inter-Plant Communication’. Symbiosis, 2022, 1–14.
Climatecentral.org. 2022. [online] Available at: <https://www.climatecentral.org/> [Accessed 29 August 2022].
Cook, Gordon Charles. ‘Construction of London’s Victorian Sewers: The Vital Role of Joseph Bazalgette’. Postgraduate Medical Journal 77, no. 914 (2001): 802–802.
Escobar, Arturo. ‘Designs for the Pluriverse’. In Designs for the Pluriverse. Duke University Press, 2018.
Fukasawa, Yu, and Koji Kaga. ‘Timing of Resource Addition Affects the Migration Behavior of Wood Decomposer Fungal Mycelia’. Journal of Fungi 7, no. 8 (2021): 654.
Fukasawa, Yu, Melanie Savoury, and Lynne Boddy. ‘Ecological Memory and Relocation Decisions in Fungal Mycelial Networks: Responses to Quantity and Location of New Resources’. The ISME Journal 14, no. 2 (2020): 380–88. Hui, Yuk. Art and Cosmotechnics. U of Minnesota Press, 2021.
Hui, Yuk, and Pieter Lemmens. Cosmotechnics: For a Renewed Concept of Technology in the Anthropocene. Routledge, 2021. Jones, Mitchell, Tien Huynh, Chaitali Dekiwadia, Fugen Daver, and Sabu John. ‘Mycelium Composites: A Review of Engineering Characteristics and Growth Kinetics’. Journal of Bionanoscience 11, no. 4 (2017): 241–57.
Maher, Mary Lou, and Douglas H. Fisher. ‘Using AI to Evaluate Creative Designs’. In DS 73-1 Proceedings of the 2nd International Conference on Design Creativity Volume 1, 2012.
Mehta, Abhimanyu, Reena Dubey, and Sumit Kumar. ‘Mycofiltration: A Step towards Sustainable Environment’. International Journal of Current Microbiology and Applied Sciences 6, no. 6 (2017): 1524–28.
Mnkandla, Sanele Michelle, and Patricks Voua Otomo. ‘Effectiveness of Mycofiltration for Removal of Contaminants from Water: A Systematic Review Protocol’. Environmental Evidence 10, no. 1 (2021): 1–8.
Olsson, Gustaf, Bengt Carlsson, Joaquim Comas, John Copp, K. V. Gernaey, P. Ingildsen, Ulf Jeppsson, C. Kim, L. Rieger, and Ignasi Rodriguez-Roda. ‘Instrumentation, Control and Automation in Wastewater–from London 1973 to Narbonne 2013’. Water Science and Technology 69, no. 7 (2014): 1373–85.
———. ‘Instrumentation, Control and Automation in Wastewater–from London 1973 to Narbonne 2013’. Water Science and Technology 69, no. 7 (2014): 1373–85.
Ongpeng, Maximino C., Edward Inciong, Vince Sendo, Crizia Soliman, and Adrian Siggaoat. ‘Using Waste in Producing BioComposite Mycelium Bricks’. Applied Sciences 10, no. 15 (2020): 5303.
Pasquero, Claudia, and Marco Poletto. ‘Beauty as Ecological Intelligence: Bioɪdigital Aesthetics as a Value System of Postɪ Anthropocene Architecture’. Architectural Design 89, no. 5 (2019): 58–65.
Solé, Ricard, Melanie Moses, and Stephanie Forrest. Liquid Brains, Solid Brains. Philosophical Transactions of the Royal Society B. Vol.
374. The Royal Society, 2019.
Stamets, Paul. Mycelium Running: How Mushrooms Can Help Save the World. Random House Digital, Inc., 2005. Stronach, Sandra M., Thomasine Rudd, and John N. Lester. Anaerobic Digestion Processes in Industrial Wastewater Treatment. Vol.
2. Springer Science & Business Media, 2012.
Taylor, Alex W., and Paul E. Stamets. ‘Implementing Fungal Cultivation in Biofiltration Systems–the Past, Present, and Future of Mycofiltration’. National Proceedings: Forest and Conservation Nursery Associations—2013 23 (2014). ———. ‘Implementing Fungal Cultivation in Biofiltration Systems–the Past, Present, and Future of Mycofiltration’. National Proceedings: Forest and Conservation Nursery Associations—2013 23 (2014).
Wandletrust.org. 2022. Mycofiltration | The Wandle Trust. [online] Available at: <https://www.wandletrust.org/tag/mycofiltration/> [Accessed 29 August 2022].
Watson, Julia, and Davis Wade. Lo-TEK. Taschen, 2017.
Willis, Anne-Marie. ‘Ontological Designing’. Design Philosophy Papers 4, no. 2 (2006): 69–92. Winograd, Terry, and Fernando F. Flores. Understanding Computers and Cognition: A New Foundation for Design. Intellect Books, 1986.
Xing, Yangang, Matthew Brewer, Hoda El-Gharabawy, Gareth Griffith, and Phil Jones. ‘Growing and Testing Mycelium Bricks as Building Insulation Materials’. In IOP Conference Series: Earth and Environmental Science, 121:022032. IOP Publishing, 2018.